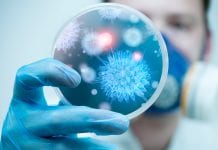

Health-015-November-2020 Related News
Mental health, COVID-19 and the workplace
The UK’s Health and Safety Executive speaks to HEQ about COVID-19 and mental health at work.
With the COVID-19 pandemic still nowhere close to a...
COVID-19 and infection control in Europe
ECDC experts Dr Agoritsa Baka and Dr Diamantis Plachouras tell HEQ about public health planning infection control policy during the COVID-19 pandemic.
The European Centre...
COVID-19 and infection control in Canada
Infection Prevention and Control Canada President Barbara Catt speaks with HEQ about Canada’s response to the COVID-19 pandemic.
Infection Prevention and Control Canada (IPAC Canada)...
Contact tracing and data protection in the UK
JMW Solicitors Head of Data Protection Toni Vitale speaks to HEQ about data security in the UK’s Test and Trace programme.
Earlier this year, the...
Jo’s Cervical Cancer Trust: cervical cancer in focus
Jo’s Cervical Cancer Trust Chief Executive Robert Music speaks to HEQ about cervical cancer screening, treatment, and research.
In the UK, around 3,200 new cases...
International Ultraviolet Association: UVC disinfection and COVID-19
Dr Jim Malley of the International Ultraviolet Association tells HEQ about the potential of UV technology in infection control.
In 2020, the issue of infection...
Hygiene compliance in preventing healthcare-associated infections
Bacterial screenings at Stockholm’s Karolinska University Hospital enabled researchers to identify and alleviate infection risks.
Up to one in 10 hospital patients will develop a...
Artificial Intelligence in healthcare and clinical practice in the COVID era
Caroline B Hing and Yasmin Antoniou of AI for Good explore the future of AI in healthcare and clinical practice.
Automation during the industrial revolution...
The Real-time Assessment of Community Transmission study
In this article, Dr Caroline Walters, Research Associate at the Faculty of Medicine, School of Public Health, Imperial College London, discusses the Real-time Assessment...
Environmental hygiene in healthcare with Clean Hospitals
HEQ speaks with Clean Hospitals about the importance of healthcare environmental hygiene for patient safety.
The COVID-19 pandemic has thrown into sharp relief a number...
ENISA discusses cyber-challenges in digital health
The EU Agency for Cybersecurity speaks to HEQ about cybersecurity and data protection in healthcare.
The European Union Agency for Cybersecurity (ENISA) is the EU’s...
Fighting for what’s right: protecting the older population
The Secretary General of the International Federation on Ageing (IFA), Dr Jane M Barratt, spoke to Health Europa Quarterly about how COVID-19 is impacting...
The vaccine industry – meeting the challenges of COVID-19
Magdalena Rodriguez de Azero, Executive Director Vaccines Europe, discusses issues around vaccine provision, including supply and increased demand, as well as vaccine hesitancy in...
Community pharmacies – ready to act as a vaccine gateway
Jan De Belie, Professional Affairs Advisor at the Pharmaceutical Group of the European Union (PGEU), spoke to Health Europa Quarterly about how community pharmacies...
Vaccination: the pathway for concrete citizens’ engagement
The involvement of civil society actors in discussions around vaccination is crucial. Cittadinanzattiva’s Mariano Votta and Daniela Quaggia outline their work in this area.
Vaccine...
UK tops excess death figures in first wave
A study from Imperial College London places England, Scotland and Wales among countries with the highest rates of excess pandemic-related deaths.
With global deaths from...
Resilient immunisation systems in Europe: a multi-stakeholder debate
Mariano Votta, Director of Active Citizenship Network, and Clifford Holt, International Editor at Health Europa Quarterly, introduce this Special Feature on the need to...
Health Europa Quarterly Issue 15
Welcome to the 15th issue of Health Europa Quarterly, which focuses on the prevention and control of the spread of infection and disease as...
The role of point-of-care testing in the time of COVID-19
Exploring the value of point-of-care C-reactive protein testing in the time of COVID-19 in patient risk assessment and monitoring.
As the healthcare industry’s understanding of...
Orbel: improving the habit of hand hygiene
Orbel is a patented, wearable hand sanitiser designed to drastically reduce the spread of infection.
According to the World Health Organization, an estimated two million...